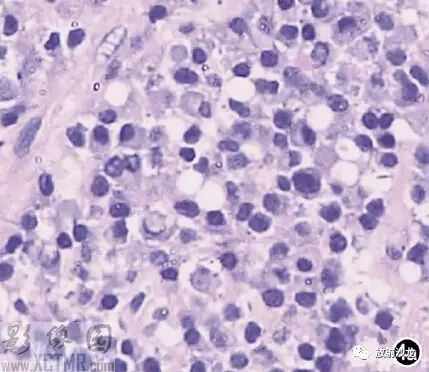

【每日一例 | 375期】食管占位性病變影像病例
病例簡介
患者,男,70歲,因進食時梗阻感及胸骨后疼痛不適3個月,胃鏡發現食管占位7d入院。
體格檢查:全身淺表淋巴結未觸及腫大。血常規正常。
胃鏡:食管距門齒18-27cm處可見腫物突向腔內,表面多光滑,可見小潰瘍形成,胃未見異常,診斷:食管癌(圖1)。
B超:肝、脾未見腫大,腹腔及腹膜后未見腫大淋巴結。
影像圖像



 解析
解析
【影像表現】
上消化道鋇餐:食管胸上段可見不規則充盈缺損,約5.6cm*4.2cm,黏膜結構紊亂,管壁不規整,對比劑通過稍緩慢,會厭動度不協調,考慮食管癌(圖2)。CT:食管胸上段見軟組織腫塊,上自杓會厭披裂,下至主動脈弓水平,腫塊邊緣清晰,密度均勻,增強掃描輕到中度不均勻強化,食管腔狹窄,氣管、右側甲狀腺、鄰近血管受壓移位(圖3),縱隔未見腫大淋巴結,診斷:食管癌可能。
【術后病理】
手術所見:腫塊位于食管,約15cm*6cm,上界到喉甲狀軟骨氣管起始處,下達胸骨后,質軟,與食管粘連緊密,周圍無明顯侵犯,無法完全切除,行活檢送病理檢查。病理:送檢組織切面呈魚肉狀;鏡下見腫瘤細胞彌漫排列,核大,深染,多圓形或不規則,部分核碎裂,胞漿淺淡,多少不等;免疫組化:S 100(-),HMB45(-),CK(-),CD3(-),CD20(+),CD45RO(-),CD79a(+),CD21散在(+),Mum-1(+),Bcl-2(-),Bcl-6(-)。診斷:(食管)非霍奇金B細胞淋巴瘤(圖4)。
【討論】
【討論】
原發于食管的惡性腫瘤多數為鱗狀細胞癌,約占98%,極少為腺癌、肉瘤、淋巴瘤。消化道是淋巴瘤易侵犯的結外器官,約占淋巴瘤的10-20%,其中胃約占48-50%,小腸約占30-37%,食管僅占1%極為罕見。
食管淋巴瘤多為全身淋巴瘤的一部分,分為原發性及繼發性,繼發性食管淋巴瘤常由胃底淋巴瘤向上蔓延或縱隔淋巴瘤直接侵犯。而本例屬原發性食管淋巴瘤,其中無論非霍奇金淋巴瘤(NHL),還是霍奇金淋巴瘤(HL),均是極為罕見。診斷原發性食管淋巴瘤必須符合以下條件:淺表淋巴結無腫大;胸部X線正常,無縱隔淋巴結腫大,若有淋巴結受侵時只能局限于唯一淋巴引流區;血常規白細胞計數正常;無其他結外器官受累。
食管淋巴瘤的影像學呈多樣化的表現形式:第一,單發或多發的食管黏膜下結節或腫塊是本病的主要征象。第二,當這些結節互相融合后其局部黏膜可以形成增粗、增厚、扭曲的縱向黏膜皺襞,形似靜脈曲張樣改變,這是另一個重要征象;本病例僅見第一個主要征象,并未觀察到第二個重要征象。在食管造影片中僅見到黏膜結構紊亂,這可能是由于某些技術上的不足所致。第三,由于增厚的縱向黏膜皺襞形成后可以產生黏膜潰瘍,發展嚴重時可以發生食管氣管瘺。本病例在胃鏡下已有小潰瘍形成,但并未發生食管氣管瘺,這是因為潰瘍尚未穿破漿膜層的緣故。第四個特點是原發性食管淋巴瘤發生的部位大多在食管的上中段,縱隔淋巴結都不增大。而且盡管腫瘤體積很大,但食管嚴重狹窄的程度卻相對不明顯。這在本病例均是符合的,而與食管癌卻是不相吻合的。食管間質瘤則病變范圍局限,與正常食道有銳利分界,黏膜光滑。由此,根據以上特點可以作出對本病的提示診斷。
X線食管硫酸鋇造影是診斷本病的首要檢查方法。CT與MRI對于食管淋巴瘤的治療前臨床分期及治療后的療效評估有重要的使用價值及實用意義,而CT則更為常用。

- 上一篇

全球一半食管癌在中國,如何規范防治?一文打盡
點擊下方鏈接,閱讀指南原文: 中國食管癌篩查與早診早治指南(2022,北京) 想查看更多食管癌指南,點擊此處1、流行病學 近年來,食管癌已經成為嚴重威脅我國居民健康的惡性腫瘤之一。截至2020年,我國已成為名副其實的食管癌大國——我國食管癌患者占全球食管癌發病與死亡人數的53.70%和55.35%。 在我國,食管癌以食管鱗狀細胞癌為
- 下一篇

Euro?Radio:用于預測食管癌患者無病生存期和總生存期的MR放射組學模型
據統計,食道癌(EC)的發病率在全球排名第七,總死亡率排名第六。食道癌是中國最常見的惡性腫瘤之一,90%以上的食道癌是鱗狀細胞癌(ESCC)。盡管有報道稱EC的總體5年生存率已從20世紀60年代的不足5%上升到近10年的約20%,但晚期患者的生存率仍不令人滿意。 根據疾病的不同階段,ESCC的治療包括手術、新輔助化療和化放療。然而,由于早期ESCC的臨床表現
